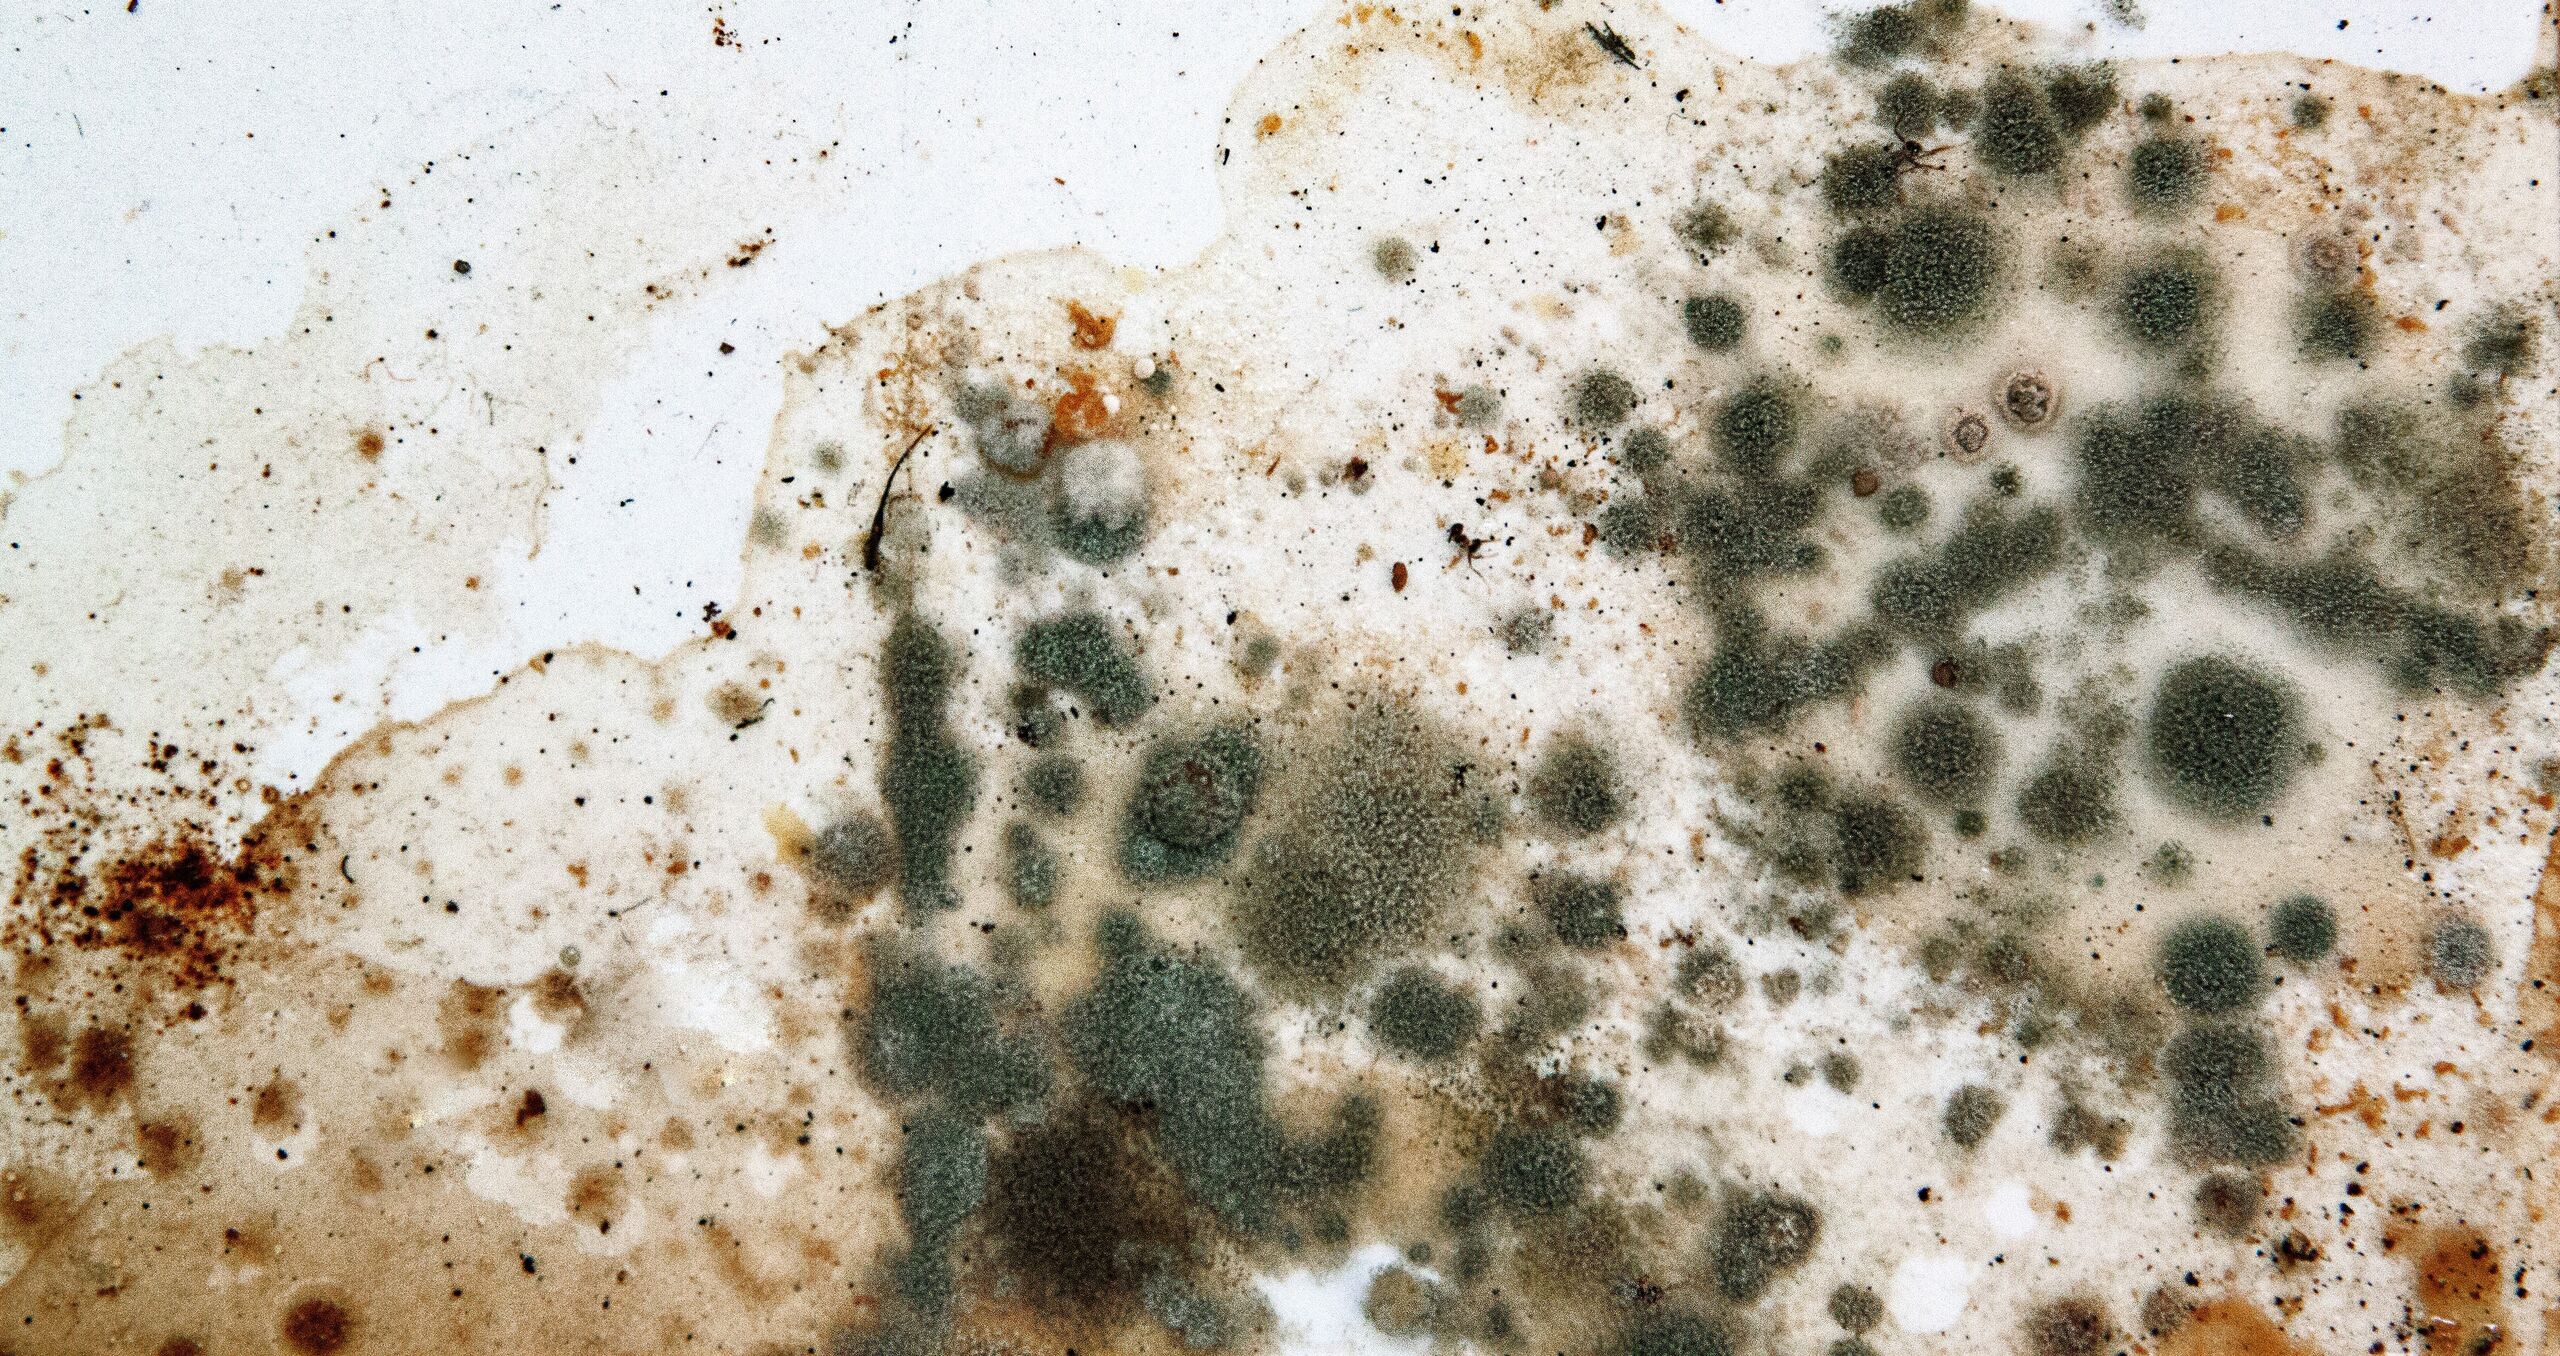

5 árulkodó jel, hogy penész van a lakásodban
Látványos elszíneződés
A penész kialakulása általában foltokban vagy elszíneződések formájában jelenik meg a falakon, a mennyezeten vagy más felületeken. Barna, fekete, vagy zöldes elszíneződések figyelmeztető jelek lehetnek.
Szag
Az első és leggyakoribb jel, amely arra utalhat, hogy otthonunkban penész szaporodik, a jellegzetes, dohos szag. Amikor ezt az aromát észleljük, érdemes alaposan átvizsgálni a lakást, különös tekintettel a nedvesebb területekre.
Ez is érdekelhet: 5 hasznos tipp, ha könnyen penészesedik a lakásod
Vízszivárgások és nem megfelelő szellőzés
A penész hátterében gyakran a különféle vízszivárgások és nem megfelelő szellőzés is állhat. A penész általában olyan helyeken jelentkezik először, ahol a pára nem tud megfelelően eltávozni: sötét, nedves helyeken, például a mosogató alatt, a hűtőszekrény mögött vagy a szekrények és kamrák sarkaiban tenyészik.
Olvasd el ezt is! Egy gomba, amely áldás a borászoknak
Hámló festék
A penész a nedves környezetet kedveli, így, ha a konyhai festék vagy tapéta alatt rejtett nedvesség rekedt, Holevich szerint ez okozhatja azok hámlását vagy buborékosodását. Ha észrevesszük, hogy a konyhai tapéta vagy festék széle felgyűrődik, akkor lehetséges, hogy penészesedéssel van dolgunk.
Gyakori légzőszervi problémák
Ha az otthonunkban penész van, az a levegő minőségének csökkenéséhez vezethet, ami légzőszervi problémákat okozhat. Allergiás reakciók, asztma és más légzőszervi megbetegedések alakulhatnak ki, különösen azoknál, akik érzékenyek rá.
Nyitókép: Shutterstock